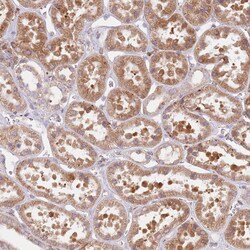
Invitrogen TPD52L2 Polyclonal Antibody 100 &mu;L; Unconjugated:Antibodies,

missing translation for 'onlineSavingsMsg'
Learn More
Learn More
Invitrogen™ TPD52L2 Polyclonal Antibody


Rabbit Polyclonal Antibody
Brand: Invitrogen™ PA561532
This item is not returnable.
View return policy
Description
Immunogen sequence: ATFKSFEDRV GTIKSKVVGD RENGSDNLPS SAGSGDKPLS DPAPF Highest antigen sequence identity to the following orthologs: Mouse - 84%, Rat - 84%.
EZH2 (Histone-lysine N-methyltransferase) is a member of the Polycomb-group (PcG) family. PcG family members form multimeric protein complexes, which are involved in maintaining the transcriptional repressive state of genes over successive cell generations. This protein associates with the embryonic ectoderm development protein, the VAV1 oncoprotein, and the X-linked nuclear protein. EZH2 may play a role in the hematopoietic and central nervous systems. Mutations affecting EZH2 can cause Weaver syndrome (WVS).
Specifications
| TPD52L2 | |
| Polyclonal | |
| Unconjugated | |
| Tpd52l2 | |
| 2810411G23Rik; AU016537; C86069; D54; DKFZp686A1765; HCCR-binding protein 2; hD54; Tpd52l2; TPD54; tumor protein D52 like 2; tumor protein D52-like 2; Tumor protein D54 | |
| Rabbit | |
| Antigen affinity chromatography | |
| RUO | |
| 296480, 66314, 7165 | |
| Store at 4°C short term. For long term storage, store at -20°C, avoiding freeze/thaw cycles. | |
| Liquid |
| Immunohistochemistry (Paraffin), Western Blot, Immunocytochemistry | |
| 0.05 mg/mL | |
| PBS with 40% glycerol and 0.02% sodium azide; pH 7.2 | |
| O43399, Q6PCT3, Q9CYZ2 | |
| Tpd52l2 | |
| Recombinant protein corresponding to Human TPD52L2. Recombinant protein control fragment (Product #RP-99303). | |
| 100 μL | |
| Primary | |
| Human, Mouse, Rat | |
| Antibody | |
| IgG |
Product Content Correction
Your input is important to us. Please complete this form to provide feedback related to the content on this product.
Product Title
Spot an opportunity for improvement?Share a Content Correction